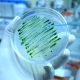

สมเด็จพระกนิษฐาธิราชเจ้า กรมสมเด็จพระเทพรัตนราชสุดาฯ สยามบรมราชกุมารี พระราชสมภพเมื่อวันเสาร์ที่ 2 เมษายน พ.ศ.2498
ทรงเข้ารับการศึกษาระดับอนุบาลที่โรงเรียนจิตรลดา จนจบมัธยมศึกษาตอนปลาย
ทรงสอบเข้าศึกษาต่อในระดับอุดมศึกษา ณ คณะอักษรศาสตร์จุฬาลงกรณ์มหาวิทยาลัย สามารถทำคะแนนสอบเอนทรานซ์เป็นอันดับ 4 ของประเทศ
เป็นสมเด็จเจ้าฟ้าพระองค์แรก ที่ทรงเข้าศึกษาต่อระดับอุดมศึกษาในประเทศ
พ.ศ. 2520 ทรงสำเร็จการศึกษาได้รับปริญญาอักษรศาสตรบัณฑิต สาขาประวัติศาสตร์ เกียรตินิยมอันดับหนึ่ง เหรียญทอง คะแนนเฉลี่ย 3.98
ระดับปริญญาโท ด้านจารึกภาษาตะวันออก (ภาษาสันสกฤตและภาษาเขมร) คณะโบราณคดี มหาวิทยาลัยศิลปากร และสาขาภาษาบาลีและภาษาสันสกฤต จาก ภาควิชาภาษาตะวันออก คณะอักษรศาสตร์ จุฬาลงกรณ์มหาวิทยาลัย
ระดับปริญญาเอก คณะศึกษาศาสตร์ มหาวิทยาลัยศรีนครินทรวิโรฒ พระองค์ผ่านการสอบคัดเลือกอย่างยอดเยี่ยมด้วยคะแนนเป็นอันดับหนึ่งในบรรดาผู้เข้าสอบทั้งหมด
ในวโรกาสวันเฉลิมพระชนมพรรษาพระบาทสมเด็จพระปรมินทรมหาภูมิพลอดุลยเดช เมื่อวันที่ 5 ธันวาคม พ.ศ.2520 มีพระบรมราชโองการสถาปนาพระอิสริยศักดิ์สมเด็จพระเจ้าลูกเธอ เจ้าฟ้าสิรินธรเทพรัตนสุดา กิติวัฒนาดุลโสภาคย์ เฉลิมพระนามตามที่จารึกในพระสุพรรณบัฏว่า “สมเด็จพระเทพรัตนราชสุดา เจ้าฟ้ามหาจักรีสิรินธร รัฐสีมาคุณากรปิยชาติ สยามบรมราชกุมารี”
เป็นสมเด็จเจ้าฟ้าหญิงพระองค์แรก ที่ทรงดำรงพระอิสริยยศที่ “สยามบรมราชกุมารี” แห่งราชวงศ์จักรี
สมเด็จพระกนิษฐาธิราชเจ้า กรมสมเด็จพระเทพรัตนราชสุดาฯ สยามบรมราชกุมารี ทรงพระอัจฉริยภาพด้านภาษา ด้านดนตรี และด้านพระราชนิพนธ์
ด้านพระราชกรณียกิจ ทรงมุ่งมั่นพัฒนา ในทุกๆ ด้าน อาทิ ด้านการศึกษา ด้านการอนุรักษ์ศิลปวัฒนธรรมไทย ด้านการพัฒนาสังคมและการพัฒนาห้องสมุดและการรู้หนังสือ ด้านการต่างประเทศ โดยเฉพาะสาธารณรัฐประชาชนจีน ด้านการสาธารณสุข และด้านศาสนา
เมื่อวันที่ 26 กุมภาพันธ์ 2528 ประกาศให้วันที่ 2 เมษายนของทุกปี เป็นวันคล้ายวันพระราชสมภพของสมเด็จพระเทพรัตนราชสุดาฯ สยามบรมราชกุมารี เป็น “วันอนุรักษ์มรดกไทย” เพื่อรณรงค์สร้างความเข้าใจ ความสำนึกรัก และหวงแหนในมรดกทางศิลปวัฒนธรรมของชาติ
6,323 total views, 308 views today